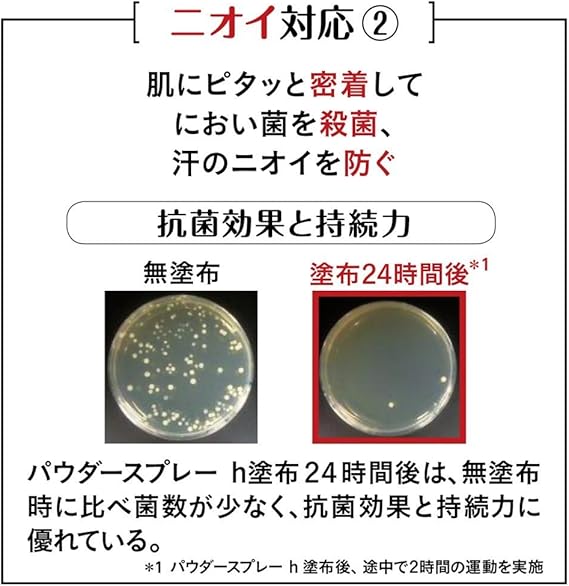

1/6
エージーデオ24 パウダースプレー 無香料 40g (医薬部外品) a
¥2,039 税込
なら 手数料無料で 月々¥670から
この商品は送料無料です。
内容量:40g
効能・効果:ワキが(腋臭)、皮ふ汗臭、制汗
スキンタイプ:全肌質対応
原産国:日本
商品サイズ (幅×奥行×高さ) :36mm×36mm×149mm
全成分:イソプロピルメチルフェノール*,焼ミョウバン*,アパサイダーC,ヒアルロン酸ナトリウム(2),合成ケイ酸ナトリウム・マグネシウム,濃グリセリン,液化石油ガス,無水エタノール,タルク,メチルフェニルポリシロキサン,無水ケイ酸,パルミチン酸4-エチルヘキシル,ポリオキシエチレン・メチルポリシロキサン共重合体,ステアリン酸カルシウ
-
レビュー
(188)
-
送料・配送方法について
-
お支払い方法について
最近チェックした商品
同じカテゴリの商品
その他の商品